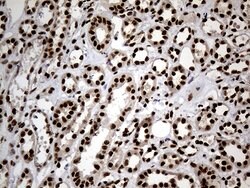
HNRNPH1 Monoclonal Antibody (OTI1H3), TrueMAB , OriGene 100 &mu;L; Unconjugated:Antibodies,

missing translation for 'onlineSavingsMsg'
Learn More
Learn More
HNRNPH1 Monoclonal Antibody (OTI1H3), TrueMAB™, OriGene
Mouse Monoclonal Antibody
Brand: Origene Technologies TA810901

This item is not returnable.
View return policy
Description
This gene belongs to the subfamily of ubiquitously expressed heterogeneous nuclear ribonucleoproteins (hnRNPs). The hnRNPs are RNA binding proteins and they complex with heterogeneous nuclear RNA (hnRNA). These proteins are associated with pre-mRNAs in the nucleus and appear to influence pre-mRNA processing and other aspects of mRNA metabolism and transport. While all of the hnRNPs are present in the nucleus, some seem to shuttle between the nucleus and the cytoplasm. The hnRNP proteins have distinct nucleic acid binding properties. The protein encoded by this gene has three repeats of quasi-RRM domains that bind to RNAs. It is very similar to the family member HNRPF. This gene is thought to be potentially involved in hereditary lymphedema type I phenotype.Specifications
| HNRNPH1 | |
| Monoclonal | |
| 1 mg/mL | |
| PBS with 1% BSA, 50% glycerol and 0.02% sodium azide | |
| P31943 | |
| HNRNPH1 | |
| Full length human recombit protein of human HNRNPH1 produced in HEK293T cell. | |
| 100 μL | |
| Primary | |
| Human | |
| Antibody | |
| IgG1 |
| Immunohistochemistry (Paraffin), Western Blot | |
| OTI1H3 | |
| Unconjugated | |
| HNRNPH1 | |
| HNRPH, HNRPH1, hnRNPH | |
| Mouse | |
| Affinity Chromatography | |
| RUO | |
| 3187 | |
| -20° C, Avoid Freeze/Thaw Cycles | |
| Liquid |
Product Content Correction
The Fisher Scientific Encompass Program offers items which are not part of our distribution portfolio. These products typically do not have pictures or detailed descriptions. However, we are committed to improving your shopping experience. Please use the form below to provide feedback related to the content on this product.
Product Title
Spot an opportunity for improvement?Share a Content Correction